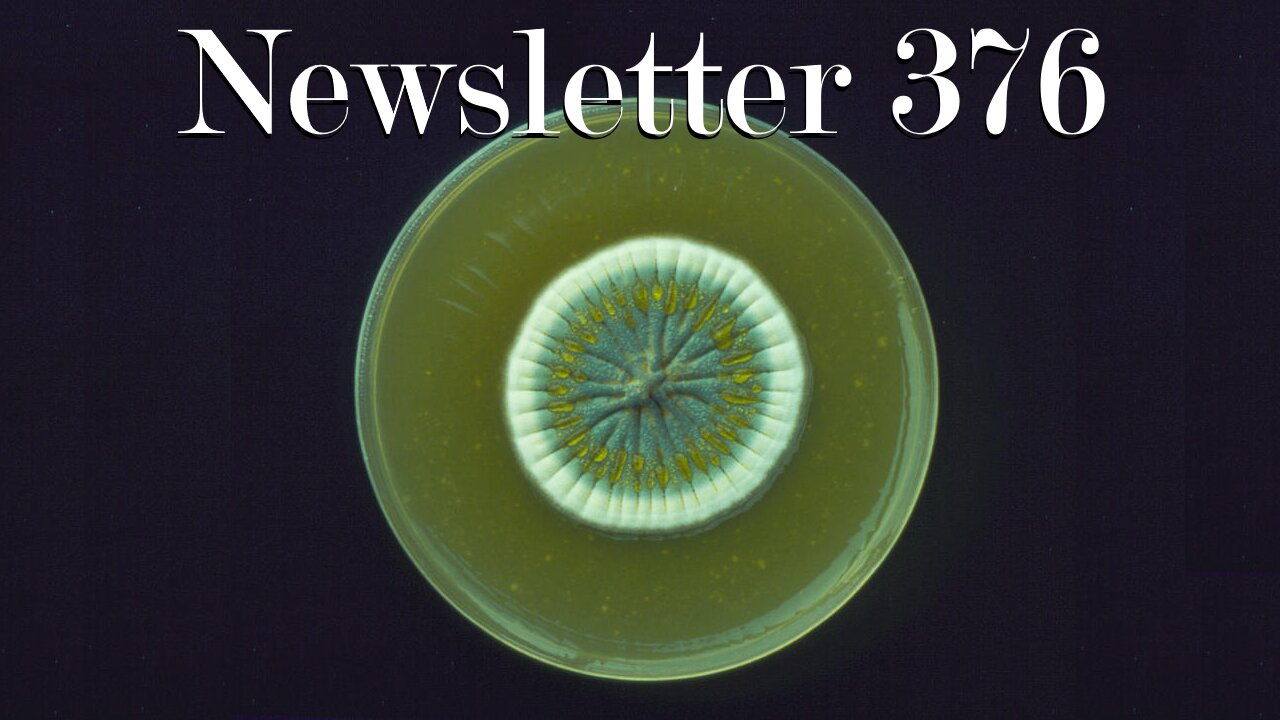
Newsletter 376: Man-Made Horrors Beyond Your Comprehension

Premium Only Content
This video is only available to Rumble Premium subscribers. Subscribe to
enjoy exclusive content and ad-free viewing.
Newsletter 376: Man-Made Horrors Beyond Your Comprehension
1 day ago
9
Newsletter 376: Man-Made Horrors Beyond Your Comprehension
Friday 16 January 2026
Grand Strategy Newsletter
The View from Oregon – 376
Man-Made Horrors Beyond Your Comprehension
https://mailchi.mp/742291a5ebcc/the-view-from-oregon-376
…in which I discuss Nikola Tesla, the Zeitgeist, when physicists knew sin, morally dubious technologies, researching consciousness, additive and subtractive engineering of the mind, brain organoids, science as a form of body horror, internalizing sacrifices for scientific knowledge, and the role suffering in the development of mind…
Loading comments...
-
 23:59
23:59
Grand Strategy: The View from Oregon
17 hours agoGomperz on Logical Positivism in Historical Research
8 -
 1:11:57
1:11:57
Russell Brand
2 hours agoCrack On: What Comes After Addiction, Chaos, and Collapse — SF671
107K23 -
 15:39
15:39
Bearing
8 hours agoANTIFA SOY SOLDIERS Are Trying to Take Minneapolis 🚨🤣
1.69K19 -
 DVR
DVR
vivafrei
4 hours agoJake Lang" Activist or PROVOCATEUR? Don Lemon to Face CHARGES? TPUSA to Sue? & MORE!
27.2K35 -
 LIVE
LIVE
Dr Disrespect
6 hours ago🔴LIVE - DR DISRESPECT - ARC RAIDERS - RAIDS AND BLADES
1,352 watching -
 19:10
19:10
Stephen Gardner
1 hour ago🚨Trump FURIOUS as Huge Lie LEAKS and Minnesota Spins OUT OF CONTROL
10.1K34 -
 1:24:08
1:24:08
HotZone
4 days ago $0.56 earnedIran Revolts Under Brutal Regime Crackdown: Why This Time Is Different
8.67K7 -
 LIVE
LIVE
LFA TV
22 hours agoLIVE & BREAKING NEWS! | MONDAY 1/19/26
1,336 watching -
 1:16:11
1:16:11
The Quartering
3 hours agoDON LEMON TO BE CHARGED! OVER 10,000 ILLEGALS ALREADY ARRESTED & SOMALI ATTACKS JOURNO!
53.2K34 -
 4:22:24
4:22:24
Joker Effect
7 hours agoRUMBLE RAIDS - RUMBLE CEO CHRIS PAV, THE QUARTERING AND THE JOKER RAID RUMBLE CREATORS!
380K22